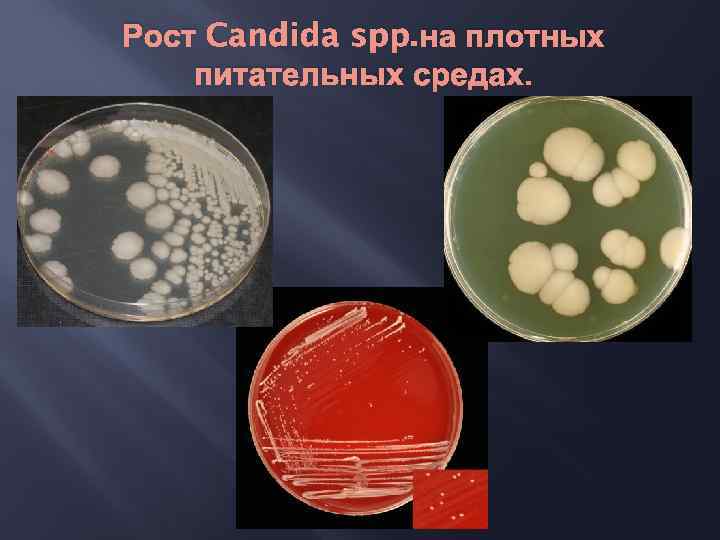
Рост Candida spp. на плотных питательных средах.

лекция по грибам 2011.pptx
- Количество слайдов: 56
 ВВЕДЕНИЕ В МЕДИЦИНСКУЮ МИКОЛОГИЮ. КАНДИДОЗЫ. к. м. н. , доц. Перунова Н. Б. октябрь 2011
ВВЕДЕНИЕ В МЕДИЦИНСКУЮ МИКОЛОГИЮ. КАНДИДОЗЫ. к. м. н. , доц. Перунова Н. Б. октябрь 2011
 ГРИБЫ – ЭУКАРИОТИЧЕСКИЕ ОРГАНИЗМЫ, ГЕТЕРОТРОФНЫЕ ПО СПОСОБУ ПИТАНИЯ, ОДНОКЛЕТОЧНЫЕ ИЛИ ОБРАЗУЮЩИЕ ВЕТВЯЩИЕСЯ НИТИ, РАЗМНОЖАЮЩИЕСЯ ПОЛОВЫМ ИЛИ БЕСПОЛЫМ ПУТЕМ С ПОМОЩЬЮ СПОР.
ГРИБЫ – ЭУКАРИОТИЧЕСКИЕ ОРГАНИЗМЫ, ГЕТЕРОТРОФНЫЕ ПО СПОСОБУ ПИТАНИЯ, ОДНОКЛЕТОЧНЫЕ ИЛИ ОБРАЗУЮЩИЕ ВЕТВЯЩИЕСЯ НИТИ, РАЗМНОЖАЮЩИЕСЯ ПОЛОВЫМ ИЛИ БЕСПОЛЫМ ПУТЕМ С ПОМОЩЬЮ СПОР.
 Строение клетки гриба - - Ядро (окружено постоянной мембраной, несколько хромосом, ядрышко) Органеллы: Митохондрии (пластинчатые с линейно расположенными кристами) Эндоплазматическая сеть Эукариотические рибосомы Микросомы Вакуолярный аппарат Наружная оболочка: Клеточная мембрана Клеточная стенка
Строение клетки гриба - - Ядро (окружено постоянной мембраной, несколько хромосом, ядрышко) Органеллы: Митохондрии (пластинчатые с линейно расположенными кристами) Эндоплазматическая сеть Эукариотические рибосомы Микросомы Вакуолярный аппарат Наружная оболочка: Клеточная мембрана Клеточная стенка
 ЗНАЧЕНИЕ ГРИБОВ (антропоморфное деление носит условный характер) Позитивное значение: Употребление в качестве продуктов питания Пищевая промышленность (производство хлеба, сыра, вина, пива) Фармацевтическая промышленность (антибиотики, каротиноиды, лимонная кислота и др. ) Уничтожение отходов (рециклизация) Негативное значение: Аллергические заболевания (обусловленные иммунологической гиперчувствительностью) Отравление грибами (образование токсинов высшими грибами) Микотоксикозы (Aspergillus, Fusarium) Микозы
ЗНАЧЕНИЕ ГРИБОВ (антропоморфное деление носит условный характер) Позитивное значение: Употребление в качестве продуктов питания Пищевая промышленность (производство хлеба, сыра, вина, пива) Фармацевтическая промышленность (антибиотики, каротиноиды, лимонная кислота и др. ) Уничтожение отходов (рециклизация) Негативное значение: Аллергические заболевания (обусловленные иммунологической гиперчувствительностью) Отравление грибами (образование токсинов высшими грибами) Микотоксикозы (Aspergillus, Fusarium) Микозы
 Penicillium chrysogenum Cephalosporium acremonium Saccharomyces boulardii
Penicillium chrysogenum Cephalosporium acremonium Saccharomyces boulardii
 Psilocybe coprophila Psilocybe montana Psilocybe cubensis
Psilocybe coprophila Psilocybe montana Psilocybe cubensis
 ВОЗБУДИТЕЛИ МИКОЗОВ УСЛОВНО-ПАТОГЕННЫЕ - ШИРОКО РАСПРОСТРАНЕНЫ В ОКРУЖАЮЩЕЙ СРЕДЕ (КОСМОПОЛИТЫ) -ОСОБООПАСНЫЕ -ВЫСОКОКОНТАГИОЗНЫЕ - ЭНДЕМИЧНЫЕ - ВХОДЯТ В СОСТАВ БИОЦЕНОЗОВ - ВЫЗЫВАЮТ ИНФЕКЦИЮ ПРИ УСЛОВИИ СНИЖЕНИЯ РЕЗИСТЕНТНОСТИ МАКРООРГАНИЗМА (ИММУНОДЕФИЦИТЫ)
ВОЗБУДИТЕЛИ МИКОЗОВ УСЛОВНО-ПАТОГЕННЫЕ - ШИРОКО РАСПРОСТРАНЕНЫ В ОКРУЖАЮЩЕЙ СРЕДЕ (КОСМОПОЛИТЫ) -ОСОБООПАСНЫЕ -ВЫСОКОКОНТАГИОЗНЫЕ - ЭНДЕМИЧНЫЕ - ВХОДЯТ В СОСТАВ БИОЦЕНОЗОВ - ВЫЗЫВАЮТ ИНФЕКЦИЮ ПРИ УСЛОВИИ СНИЖЕНИЯ РЕЗИСТЕНТНОСТИ МАКРООРГАНИЗМА (ИММУНОДЕФИЦИТЫ)
 НАДЦАРСТВО EUKARYOTA ЦАРСТВО FUNGI Chyridiomycota ТИП ФОРМАЛЬНЫЙ ОТДЕЛ Zygomycota Ascomycota Deuteromycetes Fungi imperfecti Basidiomycota
НАДЦАРСТВО EUKARYOTA ЦАРСТВО FUNGI Chyridiomycota ТИП ФОРМАЛЬНЫЙ ОТДЕЛ Zygomycota Ascomycota Deuteromycetes Fungi imperfecti Basidiomycota
 Тип: Ascomycota (32 000 видов) Класс: - Endomycetes (дрожжи) - Euascomycetes (плесневые грибы) Тип: Basidiomycota (15 000 видов) Класс: - Heterobasidiomycetes (дрожжи) - Holobasidiomycetes (плесневые грибы) Тип: Zygomycota (включает около 1000 видов) Класс: - Zygomycetes (плесневые грибы)
Тип: Ascomycota (32 000 видов) Класс: - Endomycetes (дрожжи) - Euascomycetes (плесневые грибы) Тип: Basidiomycota (15 000 видов) Класс: - Heterobasidiomycetes (дрожжи) - Holobasidiomycetes (плесневые грибы) Тип: Zygomycota (включает около 1000 видов) Класс: - Zygomycetes (плесневые грибы)

 Деление на «дрожжи» и «плесени» основаны: Культуральных особенностях: Плесени Пушистые, пигментированные колонии, созревают медленнее дрожжей (более 48 часов), появление спор (на 4 -7 сутки) отражают зрелость колонии.
Деление на «дрожжи» и «плесени» основаны: Культуральных особенностях: Плесени Пушистые, пигментированные колонии, созревают медленнее дрожжей (более 48 часов), появление спор (на 4 -7 сутки) отражают зрелость колонии.
 Дрожжи - колонии похожи на бактериальные (гладкие, пастообразные), вырастают через 24 -48 часов.
Дрожжи - колонии похожи на бактериальные (гладкие, пастообразные), вырастают через 24 -48 часов.
 Организация клеток в колониях Дрожжи: - - изолированные клетки круглой или овальной формы, размером 3 -10 мкм ( «одноклеточные организмы» ) Колонии – скопление клеток разной величины, различающиеся особенностями метаболического профиля Плесени - - образуют мицелий состоящий из переплетений тонких нитей ГИФ (нитчатые, филаментозные) гифы – трубки наполненные клеточным содержимым диаметром 0, 8 – 15 мкм наличие перегородок – «септированный» мицелий (признак «высших» грибов) несептированный (единая гигантская многоядерная клетка) – «ценоцитный» (признак «низших» грибов)
Организация клеток в колониях Дрожжи: - - изолированные клетки круглой или овальной формы, размером 3 -10 мкм ( «одноклеточные организмы» ) Колонии – скопление клеток разной величины, различающиеся особенностями метаболического профиля Плесени - - образуют мицелий состоящий из переплетений тонких нитей ГИФ (нитчатые, филаментозные) гифы – трубки наполненные клеточным содержимым диаметром 0, 8 – 15 мкм наличие перегородок – «септированный» мицелий (признак «высших» грибов) несептированный (единая гигантская многоядерная клетка) – «ценоцитный» (признак «низших» грибов)
 Плесени отвечают понятию «многоклеточность» - Мицелий (переплетение гиф гриба) ТАЛЛОМ (tallos росток) ГИФАЛЬНЫЕ КЛЕТКИ СПЕЦИАЛИЗИРОВАНЫ! - у мицелия есть «корни» - РИЗОИДЫ (rhiza – корень) – закрепление на субстрате, питание. ЭТО СУБСТРАТНЫЙ (ВЕГЕТАТИВНЫЙ) МИЦЕЛИЙ НАДСУБСТРАТНАЯ ЧАСТЬ – ВОЗДУШНЫЙ (РЕПРОДУКТИВНЫЙ) МИЦЕЛИЙ. На нем созревают репродуктивные клетки – споры (КОНИДИИ). спора гифа мицелий спора конидии ризоиды
Плесени отвечают понятию «многоклеточность» - Мицелий (переплетение гиф гриба) ТАЛЛОМ (tallos росток) ГИФАЛЬНЫЕ КЛЕТКИ СПЕЦИАЛИЗИРОВАНЫ! - у мицелия есть «корни» - РИЗОИДЫ (rhiza – корень) – закрепление на субстрате, питание. ЭТО СУБСТРАТНЫЙ (ВЕГЕТАТИВНЫЙ) МИЦЕЛИЙ НАДСУБСТРАТНАЯ ЧАСТЬ – ВОЗДУШНЫЙ (РЕПРОДУКТИВНЫЙ) МИЦЕЛИЙ. На нем созревают репродуктивные клетки – споры (КОНИДИИ). спора гифа мицелий спора конидии ризоиды
 «Диморфизм» - грибы в зависимости от условий растут как дрожжи и как плесени. Диморфизм отражает адаптацию грибов к новой среде и повышению агрессивности против хозяина. ХАРАКТЕРЕН ДЛЯ ВОЗБУДИТЕЛЕЙ СИСТЕМНЫХ (ГЛУБОКИХ) МИКОЗОВ ЧЕЛОВЕКА. - Candida albicans - Blastomyces dermatitidis - Histoplasma capsulatum - Coccidioides immitis
«Диморфизм» - грибы в зависимости от условий растут как дрожжи и как плесени. Диморфизм отражает адаптацию грибов к новой среде и повышению агрессивности против хозяина. ХАРАКТЕРЕН ДЛЯ ВОЗБУДИТЕЛЕЙ СИСТЕМНЫХ (ГЛУБОКИХ) МИКОЗОВ ЧЕЛОВЕКА. - Candida albicans - Blastomyces dermatitidis - Histoplasma capsulatum - Coccidioides immitis
 Размножение грибов. НЕПОЛОВОЕ РАЗМНОЖЕНИЕ Дрожжевые грибы размножаются почкованием Плесневые грибы размножаются путем созревания «профессиональных» спор (конидий)
Размножение грибов. НЕПОЛОВОЕ РАЗМНОЖЕНИЕ Дрожжевые грибы размножаются почкованием Плесневые грибы размножаются путем созревания «профессиональных» спор (конидий)
 ПОЛОВОЕ РАЗМНОЖЕНИЕ 3 основных способа образования половых спор у грибов 1. АСКОСПОРЫ (Аскомицеты): АСК – ask – мешок Piedra hortai, Histoplasma capsulatum, Blastomyces dermatitidis аскоспоры 2. БАЗИДИОСПОРЫ (Базидиомицеты): булавовидная клетка – БАЗИДИЯ БАЗИДИОСПОРЫ Cryptococcus neoformans базидиоспоры
ПОЛОВОЕ РАЗМНОЖЕНИЕ 3 основных способа образования половых спор у грибов 1. АСКОСПОРЫ (Аскомицеты): АСК – ask – мешок Piedra hortai, Histoplasma capsulatum, Blastomyces dermatitidis аскоспоры 2. БАЗИДИОСПОРЫ (Базидиомицеты): булавовидная клетка – БАЗИДИЯ БАЗИДИОСПОРЫ Cryptococcus neoformans базидиоспоры
 3. ЗИГОСПОРЫ (Зигомицеты): образование крупных ЗИГОСПОР Mucor зигоспоры Rzizopus
3. ЗИГОСПОРЫ (Зигомицеты): образование крупных ЗИГОСПОР Mucor зигоспоры Rzizopus
 Устойчивость грибов к неблагоприятным факторам. Длительно сохраняются в роговых пластинках волос, ногтей, патологическом материале. Выраженный фунгицидный эффект: 5% р-р фенола, 10% р-р формалина, 5% р-р хлорной извести, гипохлорид натрия. Фунгистатическое действие: перекись водорода, ментол, тимол, йод, протаргол.
Устойчивость грибов к неблагоприятным факторам. Длительно сохраняются в роговых пластинках волос, ногтей, патологическом материале. Выраженный фунгицидный эффект: 5% р-р фенола, 10% р-р формалина, 5% р-р хлорной извести, гипохлорид натрия. Фунгистатическое действие: перекись водорода, ментол, тимол, йод, протаргол.
 Общие принципы диагностики микозов. I принцип (поиск АГ). - - Экспресс-метод: Прямая микроскопия образца ткани или патологического материал (препараты с КОН, калькофлюоровым белым, окраска тушью, гистопатологические варианты окраски). Иммунологическая и молекулярно-генетическая диагностика (ИФА, ПЦР). Микологический метод: Выделение возбудителя в культуре (Сабуро, СМВ и их модификации) 22 -25 о С (37 о С), до 4 – 8 недель. Идентификация возбудителя
Общие принципы диагностики микозов. I принцип (поиск АГ). - - Экспресс-метод: Прямая микроскопия образца ткани или патологического материал (препараты с КОН, калькофлюоровым белым, окраска тушью, гистопатологические варианты окраски). Иммунологическая и молекулярно-генетическая диагностика (ИФА, ПЦР). Микологический метод: Выделение возбудителя в культуре (Сабуро, СМВ и их модификации) 22 -25 о С (37 о С), до 4 – 8 недель. Идентификация возбудителя
 II принцип (поиск специфических изменений в организме). - Серологический метод ИФА Латекс-агглютинация РИФ РСК РНГА Выявление титра АТ, нарастание АТ обязательна при подозрении на глубокие и диссеминированные микозы Аллергическая проба
II принцип (поиск специфических изменений в организме). - Серологический метод ИФА Латекс-агглютинация РИФ РСК РНГА Выявление титра АТ, нарастание АТ обязательна при подозрении на глубокие и диссеминированные микозы Аллергическая проба
 Механизмы действия антимикотиков. - - Препараты, повреждающие внешние оболочки клеток грибов Нарушающие строение КС и взаимодействующие с ЭС (полиеновые макролидные антибиотики) ФУНГИЦИДНОЕ ДЕЙСТВИЕ!!!!!!! нарушающие синтез ЭС – азолы, аллиламины, тиокарбаматы, морфолины) ФУНГИСТАТИЧЕСКОЕ ДЕЙСТВИЕ!!!!! Препараты, нарушающие синтез сфинголиипдов мембраны (гальбоналиды, хафреофунгин) ФУНГИСТАТИЧЕСКОЕ ДЕЙСТВИЕ!!!!! Препараты, нарушающие строение КС за счет взаимодействия с ее компонентами с хитином (полиоксины, противогрибковые антибиотики) ФУНГИСТАТИЧЕСКОЕ ДЕЙСТВИЕ!!!!! нарушающие синтез глюкана (противогрибковые антибиотики эхинокандины и папулокандины) ФУНГИСТАТИЧЕСКОЕ ДЕЙСТВИЕ!!!!!
Механизмы действия антимикотиков. - - Препараты, повреждающие внешние оболочки клеток грибов Нарушающие строение КС и взаимодействующие с ЭС (полиеновые макролидные антибиотики) ФУНГИЦИДНОЕ ДЕЙСТВИЕ!!!!!!! нарушающие синтез ЭС – азолы, аллиламины, тиокарбаматы, морфолины) ФУНГИСТАТИЧЕСКОЕ ДЕЙСТВИЕ!!!!! Препараты, нарушающие синтез сфинголиипдов мембраны (гальбоналиды, хафреофунгин) ФУНГИСТАТИЧЕСКОЕ ДЕЙСТВИЕ!!!!! Препараты, нарушающие строение КС за счет взаимодействия с ее компонентами с хитином (полиоксины, противогрибковые антибиотики) ФУНГИСТАТИЧЕСКОЕ ДЕЙСТВИЕ!!!!! нарушающие синтез глюкана (противогрибковые антибиотики эхинокандины и папулокандины) ФУНГИСТАТИЧЕСКОЕ ДЕЙСТВИЕ!!!!!
 Классификация современных противогрибковых средств. Антибиотики - Гризаны (Гризеофульвин) Полиены – макролиды (Амфотерицин В, Нистатин) Полипептиды – кандины (Каспофунгин) Химиотерапевтические препараты - - - Производные пиримидина (Флуцитозин) Азолы (Кетоканазол, Флуканазол) Аллиламины (Тербинафин) Тиокарбаматы (Толциклат) только местного применения! Морфолины (Аморолфин) только местного применения! Производные гидроксипиридона (Циклопирокс) только местного применения! Прочие препараты (калия иодид, ундециленовая кислота)
Классификация современных противогрибковых средств. Антибиотики - Гризаны (Гризеофульвин) Полиены – макролиды (Амфотерицин В, Нистатин) Полипептиды – кандины (Каспофунгин) Химиотерапевтические препараты - - - Производные пиримидина (Флуцитозин) Азолы (Кетоканазол, Флуканазол) Аллиламины (Тербинафин) Тиокарбаматы (Толциклат) только местного применения! Морфолины (Аморолфин) только местного применения! Производные гидроксипиридона (Циклопирокс) только местного применения! Прочие препараты (калия иодид, ундециленовая кислота)
 МИКОЗЫ, ВЫЗЫВАЕМЫЕ УСЛОВНОПАТОГЕННЫМИ ГРИБАМИ. КАНДИДОЗЫ.
МИКОЗЫ, ВЫЗЫВАЕМЫЕ УСЛОВНОПАТОГЕННЫМИ ГРИБАМИ. КАНДИДОЗЫ.
 ТАКСОНОМИЯ Надцарство: Eukaryota Царство: Fungi Формальный отдел: Deuteromycetes (Fungi imperfecti) Формальный класс: Blastomycetes Формальный порядок: Cryptococcales Формальный род: Candida
ТАКСОНОМИЯ Надцарство: Eukaryota Царство: Fungi Формальный отдел: Deuteromycetes (Fungi imperfecti) Формальный класс: Blastomycetes Формальный порядок: Cryptococcales Формальный род: Candida
 Возбудитель молочницы впервые описан Gruby в 1842 году ВЫЗЫВАТЬ КАНДИДОЗ У ЧЕЛОВЕКА МОГУТ ОКОЛО 20 ВОЗБУДИТЕЛЕЙ КАНДИДОЗА
Возбудитель молочницы впервые описан Gruby в 1842 году ВЫЗЫВАТЬ КАНДИДОЗ У ЧЕЛОВЕКА МОГУТ ОКОЛО 20 ВОЗБУДИТЕЛЕЙ КАНДИДОЗА
 Строение клеточной стенки Candida spp. многослойная (5 -8 слоев), толщиной 100 -300 нм (зависит от условий внешней среды) состав: - Маннопротеины 35 -40% -Глюканы 45 – 60% - Хитин: не более 5% (0, 5 -1%) (полимер из единиц N-ацетил глюкозамина)
Строение клеточной стенки Candida spp. многослойная (5 -8 слоев), толщиной 100 -300 нм (зависит от условий внешней среды) состав: - Маннопротеины 35 -40% -Глюканы 45 – 60% - Хитин: не более 5% (0, 5 -1%) (полимер из единиц N-ацетил глюкозамина)
 Полиморфизм (диморфизм) Candida spp. Дрожжевая фаза (бесполое размножение почкованием) преобладает в жизненном цикле Candida spp. Бесполые органы (бластоспоры) – дочерние клетки, образующиеся при почковании Переход от почкующихся клеток (дрожжевая фаза) к псевдомицелию и истинному мицелию (мицелиальная фаза) и обратно вызывается изменениями условий среды Фактор среды Дрожжевая фаза Мицелиальная фаза Температура <35 О С 37 О С Кислотность < 6, 5 ˃ 6, 5 Концентрация О 2/СО 2 ˃S
Полиморфизм (диморфизм) Candida spp. Дрожжевая фаза (бесполое размножение почкованием) преобладает в жизненном цикле Candida spp. Бесполые органы (бластоспоры) – дочерние клетки, образующиеся при почковании Переход от почкующихся клеток (дрожжевая фаза) к псевдомицелию и истинному мицелию (мицелиальная фаза) и обратно вызывается изменениями условий среды Фактор среды Дрожжевая фаза Мицелиальная фаза Температура <35 О С 37 О С Кислотность < 6, 5 ˃ 6, 5 Концентрация О 2/СО 2 ˃S
 Образование ростовых трубок • Образование гиф (мицелия) у Candida albicans и некоторых штаммов Candida tropicalis • Развиваются из бластоспор • Способны к ветвлению
Образование ростовых трубок • Образование гиф (мицелия) у Candida albicans и некоторых штаммов Candida tropicalis • Развиваются из бластоспор • Способны к ветвлению
 Антигены Candida spp. Маннаны является общим АГ для большинства видов • Белковые АГ - Протеины теплового шока - Гликолитические ферменты - Протеиназа - Белок p 43 •
Антигены Candida spp. Маннаны является общим АГ для большинства видов • Белковые АГ - Протеины теплового шока - Гликолитические ферменты - Протеиназа - Белок p 43 •
 Физиология: Факультативные анаэробы (анаэробный метаболизм особенно характерен для нитчатой фазы) • Мезофилы (оптимум температуры 25 -27 о. С, способны расти при 37 о. С ) • Время роста 48 -72 часа (до 14 суток) • Метаболизм: - поглощают и ассимилируют углеводы - синтезируют аминокислоты из простых соединений углерода и азота - нуждаются в поступлении витаминов извне (ауксотрофность) и могут сами их синтезировать (прототрофность) КРОМЕ ВИТАМИНОВ А, Е, С - неорганические компоненты среды – ионы тяжелых металлов •
Физиология: Факультативные анаэробы (анаэробный метаболизм особенно характерен для нитчатой фазы) • Мезофилы (оптимум температуры 25 -27 о. С, способны расти при 37 о. С ) • Время роста 48 -72 часа (до 14 суток) • Метаболизм: - поглощают и ассимилируют углеводы - синтезируют аминокислоты из простых соединений углерода и азота - нуждаются в поступлении витаминов извне (ауксотрофность) и могут сами их синтезировать (прототрофность) КРОМЕ ВИТАМИНОВ А, Е, С - неорганические компоненты среды – ионы тяжелых металлов •
 Факторы патогенности грибов, связанные с клеткой. Белковый состав клеточной стенки Фибриллы Обеспечивают неспецифическую адгезию Интегрин - адгезия к эндотелию и белкам внеклеточного матрикса (специфическая адгезия) Маннан клеточной стенки - пирогенная простогландинозависимая лихорадка - действует на предшественников моноцитов и супрессирует Т-лимфоциты - участие в адгезии - активизирует метаболический взрыв ПЯЛ - активизирует комплемент по альтернативному пути Формирование ростовых трубок (полиморфизм) - грибы приспосабливаются к меняющимся условиям окружающей среды - увеличение гидрофобности, способствующей адгезии к эпителию и эндотелию - адгезия к фибробластам - связывание С 3 компонента комплемента - повреждение фибриногена -
Факторы патогенности грибов, связанные с клеткой. Белковый состав клеточной стенки Фибриллы Обеспечивают неспецифическую адгезию Интегрин - адгезия к эндотелию и белкам внеклеточного матрикса (специфическая адгезия) Маннан клеточной стенки - пирогенная простогландинозависимая лихорадка - действует на предшественников моноцитов и супрессирует Т-лимфоциты - участие в адгезии - активизирует метаболический взрыв ПЯЛ - активизирует комплемент по альтернативному пути Формирование ростовых трубок (полиморфизм) - грибы приспосабливаются к меняющимся условиям окружающей среды - увеличение гидрофобности, способствующей адгезии к эпителию и эндотелию - адгезия к фибробластам - связывание С 3 компонента комплемента - повреждение фибриногена -
 Секретируемые факторы патогенности Продукция простогландинов - снижает продукцию хемокинов, ФНО Альфа - пролиферация спленоцитов в организме хозяина Каталаза - защита от перекиси водорода Фосфолипаза разрушение фосфолипидов клеточных мембран, благодаря чему осуществляется адгезия и инвазия гриба Протеиназа (разрушение белков) Экзотоксин (глиотоксин) - иммуносупрессивное действие
Секретируемые факторы патогенности Продукция простогландинов - снижает продукцию хемокинов, ФНО Альфа - пролиферация спленоцитов в организме хозяина Каталаза - защита от перекиси водорода Фосфолипаза разрушение фосфолипидов клеточных мембран, благодаря чему осуществляется адгезия и инвазия гриба Протеиназа (разрушение белков) Экзотоксин (глиотоксин) - иммуносупрессивное действие
 Факторы персистенции Антилизоцимная (разрушение лизоцима) Антикомплементарная (разрушение С 3 компонента комплемента) «Антиинтерфероновая» (разрушение интерферона) Антилактоферринновая (разрушение лактоферрина) Антииммуноглобулиновая активность (разрушение Ig A и др. )
Факторы персистенции Антилизоцимная (разрушение лизоцима) Антикомплементарная (разрушение С 3 компонента комплемента) «Антиинтерфероновая» (разрушение интерферона) Антилактоферринновая (разрушение лактоферрина) Антииммуноглобулиновая активность (разрушение Ig A и др. )
 Образование биопленок Candida spp.
Образование биопленок Candida spp.
 Формирование ассоциаций с другими условно -патогенными микроорганизмами. Стафилококки Гемолитические стрептококки Кишечные палочки Клебсиеллы Шигеллы Сальмонеллы Нейссерии Трихомонады Геликобактер Коринебактерии Псевдомонады Гарднереллы Другие грибы
Формирование ассоциаций с другими условно -патогенными микроорганизмами. Стафилококки Гемолитические стрептококки Кишечные палочки Клебсиеллы Шигеллы Сальмонеллы Нейссерии Трихомонады Геликобактер Коринебактерии Псевдомонады Гарднереллы Другие грибы
 Эпидемиология кандидозов Грибы рода Candida являются комменсалом слизистых оболочек различных биотопов организма человека (эндогенное происхождение): -ЖКТ 20 -60%, -кожа, -женская репродуктивная система (13 -29% → 83%). СОБСТВЕННАЯ МИКРОФЛОРА Способны жить в естественных условиях, (во внешней среде) (экзогенное происхождение) контаминируя : -почву, - воду, -пищевые продукты и др. БОЛЬНЫЕ, НОСИТЕЛИ, ОКРУЖАЮЩАЯ СРЕДА ГОСПИТАЛЬНАЯ ИНФЕКЦИЯ!
Эпидемиология кандидозов Грибы рода Candida являются комменсалом слизистых оболочек различных биотопов организма человека (эндогенное происхождение): -ЖКТ 20 -60%, -кожа, -женская репродуктивная система (13 -29% → 83%). СОБСТВЕННАЯ МИКРОФЛОРА Способны жить в естественных условиях, (во внешней среде) (экзогенное происхождение) контаминируя : -почву, - воду, -пищевые продукты и др. БОЛЬНЫЕ, НОСИТЕЛИ, ОКРУЖАЮЩАЯ СРЕДА ГОСПИТАЛЬНАЯ ИНФЕКЦИЯ!
 Основные предрасполагающие факторы: Физиологические иммунодефициты Генетически-детерминированные иммунодефициты Онкологические и миелолимфопролиферативные заболевания Аутоиммунные и аллергические заболевания Трансплантация органов Эндокринопатии Истощающие заболевания, лечение в отделении интенсивной терапии Антибиотикотерапия СПИД Нутритивный дисбаланс Нарушение микробиоценоза (дисбиоз)
Основные предрасполагающие факторы: Физиологические иммунодефициты Генетически-детерминированные иммунодефициты Онкологические и миелолимфопролиферативные заболевания Аутоиммунные и аллергические заболевания Трансплантация органов Эндокринопатии Истощающие заболевания, лечение в отделении интенсивной терапии Антибиотикотерапия СПИД Нутритивный дисбаланс Нарушение микробиоценоза (дисбиоз)
 Механизмы защиты макроорганизма при кандидозе. ЕСТЕСТВЕННЫЕ ФАКТОРЫ ЗАЩИТЫ: р. Н, температура, конкуренция с нормофлорой, целостность кожи и слизистых, секретируемые противомикробные факторы (трансферрин, лактоферрин, лизоцим, церулоплазмин, белки острой фазы, маннозосвязывающий протеин и др. ) ФАГОЦИТОЗ: макрофаги (МФ) и нейтрофилы (НФ) выполняют основную функцию по избавлению макроорганизма от Candida spp. ЗАХВАТ МФ – непосредственная адгезия (маннозосвязывающие рецепторы на поверхности) НФ –опосредованная адгезия (с участием опсонинов: антител и факторов комплемента) ТРУДНОСТИ ЗАХВАТА Обусловлены крупными размерами грибковой клетки (гифы, псевдогифы)
Механизмы защиты макроорганизма при кандидозе. ЕСТЕСТВЕННЫЕ ФАКТОРЫ ЗАЩИТЫ: р. Н, температура, конкуренция с нормофлорой, целостность кожи и слизистых, секретируемые противомикробные факторы (трансферрин, лактоферрин, лизоцим, церулоплазмин, белки острой фазы, маннозосвязывающий протеин и др. ) ФАГОЦИТОЗ: макрофаги (МФ) и нейтрофилы (НФ) выполняют основную функцию по избавлению макроорганизма от Candida spp. ЗАХВАТ МФ – непосредственная адгезия (маннозосвязывающие рецепторы на поверхности) НФ –опосредованная адгезия (с участием опсонинов: антител и факторов комплемента) ТРУДНОСТИ ЗАХВАТА Обусловлены крупными размерами грибковой клетки (гифы, псевдогифы)
 Средства уничтожения фагоцитированных Candida spp. Система кислородных радикалов (супероксид-анион, перекись водорода, гидроксильный радикал) Перекись водорода+хлорид-анион (деятельность миелопероксидазы) = гипохлорид (сходен с действием хлорамина) Система оксида азота (ОСНОВНОЙ ФУНГИЦИДНЫЙ МЕХАНИЗМ) - Подавление гликолиза, дыхательной цепи, нарушение метаболизма фосфатов и транспортных систем (фунгистатический → фунгицидный эффект) оксид азота + супероксид-анион = высокотоксичный радикал пироксинитрит оксид азота → дитиол-динитрозные комплексы (связывают железо) Неокислительный механизм - - - Протеолитические белки фагоцитов (дефенсины, лизоцим, лактоферрин) ↓ р. Н в фагосомах
Средства уничтожения фагоцитированных Candida spp. Система кислородных радикалов (супероксид-анион, перекись водорода, гидроксильный радикал) Перекись водорода+хлорид-анион (деятельность миелопероксидазы) = гипохлорид (сходен с действием хлорамина) Система оксида азота (ОСНОВНОЙ ФУНГИЦИДНЫЙ МЕХАНИЗМ) - Подавление гликолиза, дыхательной цепи, нарушение метаболизма фосфатов и транспортных систем (фунгистатический → фунгицидный эффект) оксид азота + супероксид-анион = высокотоксичный радикал пироксинитрит оксид азота → дитиол-динитрозные комплексы (связывают железо) Неокислительный механизм - - - Протеолитические белки фагоцитов (дефенсины, лизоцим, лактоферрин) ↓ р. Н в фагосомах
 Клинические проявления.
Клинические проявления.

 I принцип. Обнаружение возбудителя. Экспресс-метод Метод газо-жидкостной хроматографии (определение в сыворотке метаболитов гриба маннозу и арабинитол) Полимеразная цепная реакция (ПЦР) Иммуноферментный анализ Реакция иммунофлюоресценции
I принцип. Обнаружение возбудителя. Экспресс-метод Метод газо-жидкостной хроматографии (определение в сыворотке метаболитов гриба маннозу и арабинитол) Полимеразная цепная реакция (ПЦР) Иммуноферментный анализ Реакция иммунофлюоресценции
 Микологический метод. Выделение чистой культуры. Исследуемый материал: смывы и соскобы со слизистых оболочек, кожи, налет (снятый тампоном или шпателем), чешуйки мацерированного края эрозивных очагов, содержимое пустул, пораженные края ногтевой пластинки, кровь, моча, амниотическая жидкость, кал, мокрота. Посев на элективные и дифференциальнодиагностические питательные среды: -Кандид-агар - Сабуро (агар, бульон) - Bi. GGY – agar - Хромогенная среда “Albicans ID 2” Микроскопия: Обнаружение характерных дрожжевых клеток, гиф и псевдогиф в патологическом материале
Микологический метод. Выделение чистой культуры. Исследуемый материал: смывы и соскобы со слизистых оболочек, кожи, налет (снятый тампоном или шпателем), чешуйки мацерированного края эрозивных очагов, содержимое пустул, пораженные края ногтевой пластинки, кровь, моча, амниотическая жидкость, кал, мокрота. Посев на элективные и дифференциальнодиагностические питательные среды: -Кандид-агар - Сабуро (агар, бульон) - Bi. GGY – agar - Хромогенная среда “Albicans ID 2” Микроскопия: Обнаружение характерных дрожжевых клеток, гиф и псевдогиф в патологическом материале
Рост Candida spp. на плотных питательных средах.
Рост Candida spp. на плотных питательных средах.
 Рост Candida spp. на хромогенных средах. Дрожжевые грибы Цвет колоний Candida albicans Зеленый Candida kefyr Cиреневый, бледносиреневый. Candida tropicalis Синий
Рост Candida spp. на хромогенных средах. Дрожжевые грибы Цвет колоний Candida albicans Зеленый Candida kefyr Cиреневый, бледносиреневый. Candida tropicalis Синий
 Идентификация чистой культуры. Микроскопия.
Идентификация чистой культуры. Микроскопия.
 Изучение биохимической активности
Изучение биохимической активности
 - - - Определение антигенной структуры РНГА Латекс-агглютинация (моноклональные антитела, покрывающие частицы латекса. «Bichro-Latex Albicans» ) агглютинация красных частиц на зеленом фоне «+» . Изучение биологических свойств Факторов вирулентности Факторов персистенции Исследование чувствительности к антимикотикам Чашечный метод Метод серийных разведений
- - - Определение антигенной структуры РНГА Латекс-агглютинация (моноклональные антитела, покрывающие частицы латекса. «Bichro-Latex Albicans» ) агглютинация красных частиц на зеленом фоне «+» . Изучение биологических свойств Факторов вирулентности Факторов персистенции Исследование чувствительности к антимикотикам Чашечный метод Метод серийных разведений
 II принцип. Обнаружение специфических изменений в организме. Серологические исследования следует проводить при подозрении на глубокий кандидоз. Трудность интерпретации и сомнительность СИ связаны с ранним знакомством с АГ Candida spp. (выработка АТ вскоре после рождения) , наличие АТ (Ig. G, преципитинов) отражает факт носительства. Целесообразно определять Ig. E к АГ Candida spp. при хронической кандидозной инфекции. ИСПОЛЬЗУЮТСЯ: Радиальная иммунодиффузия по Манчини Встречный иммуноэлектрофорез Латекс-агглютинация РНГА ИФА РИА Радиоаллергосорбентный тест (RAST)
II принцип. Обнаружение специфических изменений в организме. Серологические исследования следует проводить при подозрении на глубокий кандидоз. Трудность интерпретации и сомнительность СИ связаны с ранним знакомством с АГ Candida spp. (выработка АТ вскоре после рождения) , наличие АТ (Ig. G, преципитинов) отражает факт носительства. Целесообразно определять Ig. E к АГ Candida spp. при хронической кандидозной инфекции. ИСПОЛЬЗУЮТСЯ: Радиальная иммунодиффузия по Манчини Встречный иммуноэлектрофорез Латекс-агглютинация РНГА ИФА РИА Радиоаллергосорбентный тест (RAST)
 Лечение ЭТИОТРОПНОЕ • • Противогрибковый антибиотик группы полиенов-макролидов (Нистатин, Амфотерицин В, липидная форма Амфотерицина В) Противогрибковый антибиотик группы гризанов (Гризеофульвин) Азолы (Флуконазол, Итраконазол) Аллиламины (Тербинафин, Бутенафин) Тиокарбаматы (Толциклат) Произволные морфолина (Аморолфин) Производные гидроксипиридона (Циклопирокс) СИМПТОМАТИЧЕКОЕ • Лечение основного заболевания • Коррекция дисбиоза • Иммуномодулирующ ие препараты • Витаминотерапия и др.
Лечение ЭТИОТРОПНОЕ • • Противогрибковый антибиотик группы полиенов-макролидов (Нистатин, Амфотерицин В, липидная форма Амфотерицина В) Противогрибковый антибиотик группы гризанов (Гризеофульвин) Азолы (Флуконазол, Итраконазол) Аллиламины (Тербинафин, Бутенафин) Тиокарбаматы (Толциклат) Произволные морфолина (Аморолфин) Производные гидроксипиридона (Циклопирокс) СИМПТОМАТИЧЕКОЕ • Лечение основного заболевания • Коррекция дисбиоза • Иммуномодулирующ ие препараты • Витаминотерапия и др.
 Профилактика • Выявление больных и их лечение • Санация носителей Асептика и антисептика • Предупреждение развития кандидоза у больных, страдающих тяжелыми соматическими и иммунодефицитными заболеваниями • Предупреждение развития кандидоза у новорожденных ИММУНИТЕТ! МИКРОБИОЦЕНОЗ!
Профилактика • Выявление больных и их лечение • Санация носителей Асептика и антисептика • Предупреждение развития кандидоза у больных, страдающих тяжелыми соматическими и иммунодефицитными заболеваниями • Предупреждение развития кандидоза у новорожденных ИММУНИТЕТ! МИКРОБИОЦЕНОЗ!

 Антигены Candida spp. Маннаны Основной скелет маннанов содержит α-1, 6 связи и является общим АГ для большинства видов (разницу в строении маннана и АГ структуре обеспечивают боковые цепи) - фактор 1 (общий АГ, маннозид с О-связью) - фактор 9 (общий АГ, фрагмент основного скелета с α-1, 6 гликозидной связью и содержащий β-1, 2 связи) - фактор 8 (α-1, 6 – остаток+2 боковые α-1, 2 связи) - фактор 34 (конечный линейный маннозид с α-1, 3 связью) • Белковые АГ - Протеины теплового шока (располагаются в клеточной стенке, hsp 90 k. D и hsp 70 k. D) - Гликолитические ферменты (енолаза, альдолаза, фосфоглицераткиназа) - Протеиназа - Белок p 43 (способствует пролиферации В лимфоцитов, препятствует развитию защитного иммунитета) •
Антигены Candida spp. Маннаны Основной скелет маннанов содержит α-1, 6 связи и является общим АГ для большинства видов (разницу в строении маннана и АГ структуре обеспечивают боковые цепи) - фактор 1 (общий АГ, маннозид с О-связью) - фактор 9 (общий АГ, фрагмент основного скелета с α-1, 6 гликозидной связью и содержащий β-1, 2 связи) - фактор 8 (α-1, 6 – остаток+2 боковые α-1, 2 связи) - фактор 34 (конечный линейный маннозид с α-1, 3 связью) • Белковые АГ - Протеины теплового шока (располагаются в клеточной стенке, hsp 90 k. D и hsp 70 k. D) - Гликолитические ферменты (енолаза, альдолаза, фосфоглицераткиназа) - Протеиназа - Белок p 43 (способствует пролиферации В лимфоцитов, препятствует развитию защитного иммунитета) •
 Общие положения диагностики и лечения: Для кандидоза слизистых оболочек необходим дифференциальный диагноз кандидоносительства и кандидоза. Рекомендуется несколько биопсий слизистой оболочки. Необходимо стремиться к обнаружению видовой идентификации Candida и определению индивидуальной чувствительности штамма к антимикотикам. Случайная находка кандидоза - стимул к диагностике фонового фактора. Подтверждение диагноза кандидоза дифференцируемого заболевания. Дозировка и длительность антифунгального лечения зависят от фонового фактора и ответа на терапию. Общие принципы лечения; коррекция фактора риска, рациональная антифунгальная терапия, иммунокоррекция. не исключает
Общие положения диагностики и лечения: Для кандидоза слизистых оболочек необходим дифференциальный диагноз кандидоносительства и кандидоза. Рекомендуется несколько биопсий слизистой оболочки. Необходимо стремиться к обнаружению видовой идентификации Candida и определению индивидуальной чувствительности штамма к антимикотикам. Случайная находка кандидоза - стимул к диагностике фонового фактора. Подтверждение диагноза кандидоза дифференцируемого заболевания. Дозировка и длительность антифунгального лечения зависят от фонового фактора и ответа на терапию. Общие принципы лечения; коррекция фактора риска, рациональная антифунгальная терапия, иммунокоррекция. не исключает
 «Определитель патогенных и условно-патогенных грибов» . (Д. Саттон, А. Фотергилл, М. Ринальди)
«Определитель патогенных и условно-патогенных грибов» . (Д. Саттон, А. Фотергилл, М. Ринальди)


